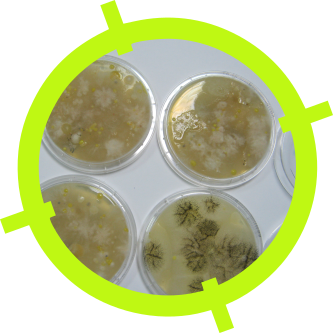

Qwalilab
QWALILAB est un laboratoire d’analyses de l’eau et des aliments de l’île de la Réunion. Nous proposons à toutes les entreprises et collectivités locales, pouvoirs publics et industriels, une prestation globale pour l’analyse des échantillons :
• Prélèvement sur site par des techniciens formés aux bonnes pratiques,
• Transport,
• Analyse,
• Transmission des résultats.
QWALILAB met à la disposition de ses clients deux centres de compétences :
• un laboratoire de microbiologie
• un laboratoire de physico-chimie
Ces deux laboratoires sont équipés d’appareils analytiques performants faisant appel à des technologies de pointe.
Le laboratoire QWALILAB est accrédité COFRAC depuis 2009 pour des analyses des périmètres suivants :
• Analyses microbiologiques des produits agro alimentaires
• Analyses microbiologiques et biologiques des eaux
ANALYSES
Analyses microbiologiques
Nous réalisons les analyses suivantes :
• Flore mésophile aérobie totale,
• Flore mésophile aérobie revivifiable 22°C/36°C,
• Entérobactéries,
• Coliformes / Coliformes thermotolérants,
• Escherichia Coli,
• Staphylocoques à coagulase positive,
• Bactéries sulfito réductrices qui se développe en conditions anaérobies,
• Clostridium perfringens,
• Bacilus cereus présomptifs
• Bactéries lactiques mésophiles
• Levures et moisissures
• Salmonella spp
• Listeria monocytogènes
• Enterocoques intestinaux
• Pseudomonas aeruginosa
• Legionelle
• Campylobacter
• Vibrio
• E.Coli O157
• Bactéries coliformes / E.Coli
• Les œufs d’helminthes
• Shigella
Analyse produits agroalimentaires
L’étiquetage nutritionnel est primordial pour le consommateur. Les informations couvrent la composition du produit et les valeurs énergétiques.
Nous vous proposons les analyses des composants suivants :
• Valeurs énergétiques
• Protéines
• Matières grasses / Lipides
• Acides gras saturés
• Glucides
• Fibres
• Vitamines
• Additifs et colorants
• Sel
Analyse des indices de qualité et des contaminants
Nos analyses de contaminants dans les produits agroalimentaires permettent à nos clients de vérifier que leurs matières premières et produits finis respectent la réglementation en vigueur.
Notre portefeuille de tests couvre les analyses suivantes :
• Métaux lourds (cadmium, plomb, etc.)
• Mercure
• Antibiotiques et hormones
• Mycotoxines
• HAP
• Histamine
• ABVT
• Indices d’oxydation (indice de peroxyde, indice d’iode, indice d’anisidine)
• Antioxydants (BHA, BHT, Ethoxyquine)
Analyses environnementales
Nous accompagnons nos clients dans leur démarche de contrôle qualité et proposons des services d’analyses environnementales des eaux et des sols.
Eaux
Nous offrons un large éventail de tests en accord avec les lois et les réglementations en vigueur pour les catégories suivantes :
• eaux potables
• eaux de surface
• nappes phréatiques
• eaux de process
• eaux de rejet
• eaux des établissements de santé
Sols et sédiments
Nous aidons nos clients dans le domaine agroalimentaire à mieux connaitre la composition de leurs sols (N, P, K, oligo-éléments, etc)
Nous offrons aussi un service pour les contaminants des sols et des sédiments incluant :
• Pesticides
• Métaux lourds
• HAP
• HCT
• PCB
• Dioxines
www.qwalilab.fr